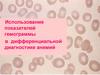
Показатели гемограммы в дифференциальной диагностике анемий

Похожие презентации:
Многофункциональность систем капиллярного электрофореза
1.
Многофункциональностьсистем определения
гликированного гемоглобина.
Зачем она нужна?
Комарова Ирина Николаевна
к.б.н., ЗАО «Фирма ГАЛЕН»
2.
В 2011 г. компания Sebia выпустилауникальный для международного
лабораторного рынка продукт – системы
капиллярного электрофореза, сочетающие
в себе форезную классику и оценку
гликированного гемоглобина
Capillarys 2 Flex Piercing
Minicap
3.
С коммерческой точки зрения сочетание«2 в одном» (белковый форез + HbA1c)
в одном анализаторе без потерь
аналитической точности безусловно
значимо и не может не привлекать
лаборатории, чей функционал включает
как выполнение ЭФ тестов, так и оценку
гликированного гемоглобина.
Однако существует ли «клиническая»
целесообразность такого сочетания?
4. ЭФ белковых фракции + HbA1c = ??
1. Диабет и миеломаВ 2011 г. в американском издании журнала
“Endocrinology” вышла статья,
акцентирующая внимание эндокринологов и
онкологов на частоте встречаемости 2-х
патологических состояний, диабета и
миеломы, и необходимости их совместного
мониторинга
5. Диабет и миелома
• Диабет – эпидемия 21 века (свыше 300 млн.больных)
• 8-20% онкологических больных страдают диабетом
• Миелома – 10% от всех видов рака крови
Вероятность сочетания у одного пациента диабета и
миеломы достаточна высока: у 11-22% пациентов с
миеломой отмечают повышение уровня HbA1c или
имеется клиническая картина диабета
6.
Диабет и миеломаМикро- и макрососудистые осложнения, возникающие в случае развития
миеломы у пациента с диабетом могут носить более тяжелый характер и
требуют специального подхода для их минимизации = > крайне важным
является вовремя оценить присутствие или риск развития у пациента с
диабетом гаммапатий => требуется скрининг М-градиента
ЦЕЛЕСООБРАЗНОСТЬ ПРОВЕДЕНИЯ ЭФ БЕЛКОВЫХ ФРАКЦИЙ
ЦЕЛЕСООБРАЗНОСТЬ ОЦЕНКИ HbA1c
Терапия глюкокортикоидами входит в основную схему лечения миеломы.
Прием глюкокортикоидов пациентами с диабетом многократно повышают
риск осложнений и смертности.
Назначение терапии должно проводиться при строгом контроле гликемии.
У пациентов с сочетанием «миелома/ диабет» терапевтическая схема
должна исключать прием глюкокортикоидов, а все прочие схемы лечения
назначаться при строгом контроле уровня HbA1c.
7.
Вывод: возможность определять HbA1c и проводить ЭФскрининг и детекцию М-градиента имеет высокую
«клиническую» значимость
Функционал капиллярных систем Sebia позволяет выполнять
данные тесты при помощи одного анализатора
БФ
Иммунотипирование
+ HbA1c
8.
Гемоглобины + HbA1c = ??• Около 7% мирового населения являются носителями
гемоглобинопатий
• 300 000 – 500 000 детей ежегодно рождаются с тяжелыми
гомозиготными состояниями гемоглобинопатий
(Всемирный Банк, 2006, отчет о совместном
совещании ВОЗ и организации March of Dime, 2006)
• Общепризнанно, что гемоглобинопатии не ограничены
каким-либо отдельным регионом, а являются широко
распространенными по всему миру заболеваниями и
представляют собой глобальную проблему
общественного здравоохранения.
9.
Первоначально считалось, что проблемагемоглобинопатий актуальна только для
тех стран, где малярия была и остается
эндемическим заболеванием.
На протяжении многих лет распространение
гемоглобинопатий действительно
ограничивалось территориями этих
стран.
10.
Однако повсеместная миграция населения из эндемических районовпривела к широкому распространению гемоглобинопатий в страны,
где прежде они встречались крайне редко.
Страны, где миграция произошла около 50-100 лет назад (США,
Канада, Австралия, Южная Америка, Великобритания и Франция),
имеют сейчас 3-5 поколение носителей генов гемоглобинопатий
Более поздние миграционные потоки из высоко эндемичных стран
были направлены в Северную и Западную Европу (Германия,
Бельгия, Нидерланды, Скандинавия)
11.
?До недавнего времени считалось, что в России встречаемость
гемоглобинопатий крайне низкая. И потому ни диагностика
самих гемоглобинопатий, ни оценка возможных
интерференций вариантных гемоглобинов на точность
измерения HbA1c не являлись актуальными.
Тем не менее сегодня существует большое число
предпосылок, которые прямо или косвенно указывают на
значительную недооценку этой проблемы в России.
12. Предпосылка №1. Миграционные потоки
Согласно докладу ООН Россия находится навтором месте (после США) по числу
законных и нелегальных иммигрантов,
проживающих на территории страны. По
оценке экспертов ООН, в России более
13 млн. мигрантов —
9 % населения.
13. Структура миграционного прироста России в обмене со странами СНГ, %
Западные страны15%
Закавказье
21%
Казахстан
29%
Средняя Азия
35%
Более 63% мигрантов
составляют выходцы из
стран Средней Азии и
Закавказья, где
распространенность
гемоглобинопатий и в
первую очередь
талассемий достаточно
высока.
Миграция в современной России.
ЖАННА ЗАЙОНЧКОВСКАЯ К.ГЕОГ.Н., РУКОВОДИТЕЛЬ ЛАБОРАТОРИИ АНАЛИЗА И ПРОГНОЗИРОВАНИЯ МИГРАЦИИ ИНСТИТУТ
НАРОДНОХОЗЯЙСТВЕННОГО ПРОГНОЗИРОВАНИЯ РАН, ЭКСПЕРТ РСМД
14. Предпосылка №2. Многонациональный состав РФ
По данным Росстата в РФ на постоянной основе проживает свыше 3% (> 4 млн.)человек кавказских и среднеазиатских национальностей, многие из которых
относятся к «группе риска» по распространенности гемоглобинопатий.
Качественные и количественные гемоглобинопатии наиболее распространены
среди таких национальностей, как Азербайджане (до 10-12%), Дагестанцы
(5-7%), Таджики и Узбеки (до 15% носительства генов талассемии).
В Европейской части России достаточно высок уровень талассемии в
Поволжье преимущественно среди татар и русских.
15.
А также:- Смешанные браки,
- Многодетные семьи в семьях из «группы
риска»,
- Рост числа больных с диагнозом «анемия
неясной этиологии»
16.
В связи с недооценкой степенираспространенности гемоглобинопатий
лаборатории и клиницисты в России, как
правило, не уделяют никакого внимания
тому, насколько сильно могут искажаться
результаты оценки HbA1c в случае
присутствия у обследуемого вариантных
гемоглобинов
17.
Даже если предположить, что сам фактналичия у пациента с диабетом
гемоглобинопатий, безразличен
клиницисту-эндокринологу («не мой
профиль»), пренебрежение данной
«отягощенностью» может значительным
образом отразиться на эффективности
терапии самого диабета
И вот почему…
18. HbA1c - это показатель гликирования гемоглобина; т.к. эритроциты живут около 120 дней, HbA1c отражает средний уровень гликемии за последние 3 месяц
HbA1c - это показатель гликированиягемоглобина; т.к. эритроциты живут около
120 дней, HbA1c отражает средний уровень
гликемии за последние 3 месяца
Любые физиологические и
патологические изменения
продолжительности жизни эритроцитов
приведут к клинически обусловленной
интерференции
19.
Влияние продолжительности жизни эритроцитовна оценку HbA1c
1. Продолжительность жизни эритроцитов сложно измерить
2. В целом она варьирует от 100 до 140 дней (в среднем –
120 дней)
3. Принятое значение – 120 ± 10 дней
4. Если целевое значение HbA1c при мониторинге диабета
составляет 7,0% для эритроцитов, живущих 120 дней, то
для эритроцитов, живущих:
•. 110 дней - 6,4%
•. 130 дней – 7,6%
The Pros and the Cons of using HbA1c for Diabetes Diagnosis
David B.Sacks; AACC Webinar April 10th 2012
20.
Средняя продолжительность жизни эритроцитов угематологически здоровых лиц и у лиц с
гемоглобинопатиями
Hb
Средняя продолжительность жизни эритроцитов в днях (n)
Hb A
120
Hb S
93 (3)
Hb E
Нет данных
Hb C
87 (6)
Hb D
115 (3)
Impact of hemoglobin variants on Hb A1c interpretation: Do we assume too much?
Jeanne M. Rhea, PhD, Tiffany K. Roberts-Wilson, PhD, and Ross J. Molinaro, PhD, MT
MLO - June 2012
21.
Продолжительность жизни эритроцитов у гетерозигот по бетаталассемии варьируетот 81 до 93 дней
22. Как правило, у гетерозигот гемоглобинопатии протекают асимптоматично Когда у таких пациентов проводят анализ HbA1c, клиницисты в большинств
Как правило, у гетерозиготгемоглобинопатии протекают
асимптоматично
Когда у таких пациентов проводят анализ
HbA1c, клиницисты в большинстве случаев
не имеют информации о том, что
гемоглобинопатия, имеющаяся у данного
пациента, может привести к клинически
обусловленной интерференции:
результаты интерпретируются вслепую
23.
Любой метод оценки HbA1c должен:• Иметь возможность детектировать наиболее
распространенные гемоглобинопатии, включая
варианты гемоглобинов и талассемии
• Обеспечивать отсутствие интерференции
гемоглобинопатий на оценку гликогемоглобина
Для того, чтобы:
• Предоставить клиницисту полную информацию о
физиологических и патологических особенностях
пациента, которые могут привести к неправильной
интерпретации результатов HbA1c
• Обеспечить точный количественный анализ HbA1c
несмотря на наличие этих особенностей
24.
В случае наличия у пациента гемоглобинопатии• Целевые значения HbA1c, выбранные в
качестве критерия для оценки
терапевтического эффекта, могут быть
неприменимы
• Требуется подтверждение при помощи
исследования на варианты гемоглобинов
25.
Талассемии и их интерферирующее воздействие на точность количественнойоценки HbA1c
Одним из признаков бетаталассемий является повышение
уровня гемоглобина А2.
Даже если эндокринолог не
заинтересован в выявлении самой
бета-талассемии («не мой
профиль»), лаборатория обязана
использовать тот метод оценки
HbA1c, который способен отделить
потенциально повышенную
фракцию А2 от целевых фракций –
HbA0 и HbA1c
26.
Талассемии и их интерферирующее воздействие на точность количественнойоценки HbA1c
Методы, не способные четко разделять пики
HbA0 и HbA2, неизбежно «загрязнят»
знаменатель расчетной
HbA2 формулы IFCC =>
уровень HbA1c будет ЗАНИЖЕН!
27.
Скрининг бета-талассемий методомкапиллярного электрофореза
Восклицательный знак (!) при повышении HbA2
свыше 3%
28.
Интерферирующее воздействие вариантов гемоглобина на точностьколичественной оценки HbA1c
Результаты сравнительного
испытания 23 коммерческих
методов оценки HbA1c,
опубликованные в журнале
Clinical Chemistry 54:8 (2008),
показали, что достаточно
точные в отсутствии
интерферентов методы
демонстрируют существенное
отклонение от целевых
значений HbA1c в
присутствии в образцах
гемоглобина D и E
29. Hb A/S
Варианты гемоглобинов и капиллярный ЭФHb A/S
Нет влияния на результат оценки HbA1c
30. Hb A/D
Варианты гемоглобинов и капиллярный ЭФHb A/D
Нет влияния на результат оценки HbA1c
31. Hb A/E
Варианты гемоглобинов и капиллярный ЭФHb A/E
Нет влияния на результат оценки HbA1c
32. Hb A/C
Варианты гемоглобинов и капиллярный ЭФHb A/C
Нет влияния на результат оценки HbA1c
33.
Аналитические характеристики систем Sebia5) Согласно данным, размещенным на сайте NGSP, являются единственными
анализаторами HbA1c без интерферирующего воздействия наиболее
распространенных вариантов гемоглобина
Method
Интерференция
HbC
Интерференция
HbS
Интерференция
HbE
Интерференция
HbD
Интерференция
повышенного HbF
Sebia Capillarys 2 Flex Piercing
НЕТ
НЕТ
НЕТ
НЕТ
НЕТ
34.
Многофункциональностьсистем капиллярного
электрофореза – она
действительно значима!
Спасибо за внимание!


































 Медицина
Медицина